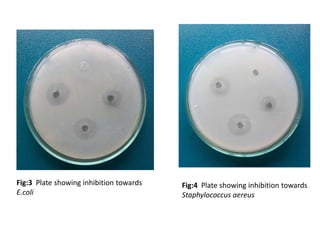
Fig:3 Plate showing inhibition towards
E.coli
Fig:4 Plate showing inhibition towards
Staphylococcus aereus

The document evaluates the antimicrobial activity of bacteriocin produced by Lactobacillus isolated from curd samples against human pathogens. Lactic acid bacteria were isolated from curd using MRS media and identified through morphological and biochemical tests as Lactobacillus species. The isolated Lactobacillus strains were screened for their ability to produce bacteriocin exhibiting antagonistic activity against indicator strains like E. coli and Staphylococcus aureus using agar well diffusion assays. Clear inhibition zones were observed around the wells indicating the isolated Lactobacillus strains could produce bacteriocin with antimicrobial activity against pathogens.